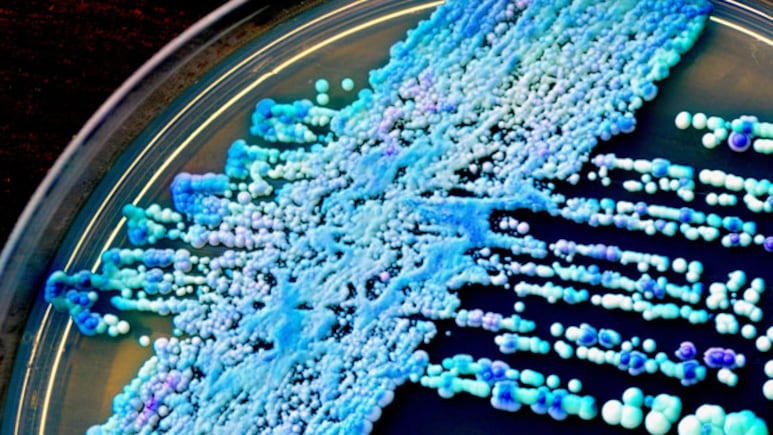
Deadly Drug-Resistant Fungus Spreading Globally, Says New Indian Study

The drug-resistant fungal species Candida auris is turning more deadly and is also spreading globally, according to a study led by Indian researchers. Candida auris is a multidrug-resistant fungal pathogen that has a unique ability to grow and persist on human skin. The study by researchers from the Vallabhbhai Patel Chest Institute, University of Delhi, in collaboration with the team at the National Institutes of Health in the US, showed that invasive fungal infections are spreading across the globe, and gaining in virulence, affecting about 6.5 million people per year. These infections are frequently associated with high mortality rates, often exceeding 50 per cent, even with antifungal therapy.
“C. auris has developed wily cellular strategies to survive, including morphogenesis in its ability to switch from yeast growth to filament-driven spread, as well as forming multicellular aggregates, and also switching its phenotypic genetic expression in response to its changing environment,” said the team in the paper published in the journal Microbiology and Molecular Biology Reviews.
The fungus is also extremely successful in colonising human skin, with the molecular evidence showing so far that the proteins of the cell wall attach like a kind of glue to mammalian cells -- and even non-living surfaces.
Long-term skin colonisation by C. auris is a significant medical concern because colonised patients may facilitate inter- and intra-hospital transmission of C. auris to other patients.
Furthermore, C. auris-colonised patients are at risk of developing more serious systemic infections, the team said.
While the host develops mechanisms to battle C. auris, the science so far indicates the germ can develop proactive ways to evade the immune response.
Diagnostics also remain a challenge, since most conventional lab tests lead to misidentification as other related yeasts, which delays and complicates treatment.
But awareness of the burden of this relatively new scourge is growing -- and research is now proliferating to catch up to clinical needs.
"Taken together, these data underscore the need to develop novel antifungal agents with broad-spectrum activity against human fungal pathogens, to improve diagnostic tests, and to develop immune- and vaccine-based adjunct modalities for the treatment of high-risk patients," the researchers write.
The study also called for efforts to raise awareness about fungal disease through developing better surveillance mechanisms, especially in resource-poor countries.
(Except for the headline, this story has not been edited by NDTV staff and is published from a syndicated feed.)
Track Latest News Live on NDTV.com and get news updates from India and around the world



